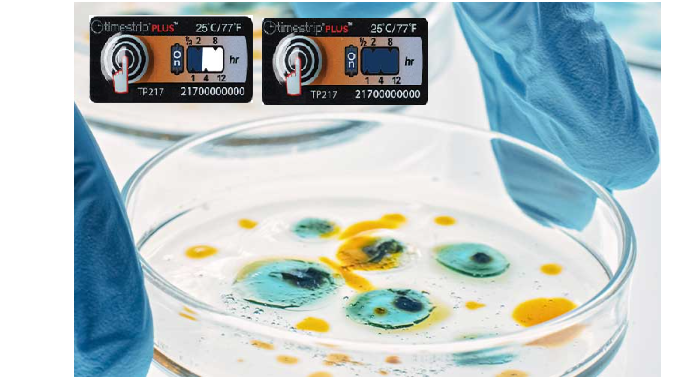

TTIラベルとは
TTIラベル(Time Temperature Indicator:時間温度インジケータ)とは、
製品が「どのくらいの時間、どの温度環境にさらされたか」を一目で判断できるラベルです。
- 温度×時間を可視化
- コールドチェーン品質管理
- 医薬品・食品・精密品に対応
- 不可逆的に変色
SpotSee®社
米国に本社を置き、世界の品質管理とコールドチェーンを支えるグローバル企業です。
同社のTTIラベルは、医薬品・バイオ・高付加価値食品向けに設計された、精度・再現性・国際規格対応を重視したプロフェッショナル仕様となっています。
SpotSee®商品を見る
SpotSee® WarmMark® / WarmMark QR



WarmMark®
過去に温度逸脱があったかどうかだけでなく、
その温度に「どれくらいの時間」さらされたかを確実に記録。
一定温度超過を色変化で即座に示すとともに、曝露時間の長さを段階的に可視化し、受入・使用可否の判断をその場で可能にします。
WarmMark® QR
温度逸脱の有無だけでなく発生時間や場所をQRコードで共有し、クラウド上で一元管理。
現場判断と品質部門の情報差をなくし、迅速で確実な初動対応を可能にします。
SpotSee® 温度降下検知ラベル ColdMark® / FreezeSafe / ColdChain Complete



ColdMark®
規定温度を一度でも下回ると不可逆に反応し、低温・凍結リスクの有無を一目で判別可能。
受入時や使用前に専門知識や機器を必要とせず確認でき、初動対応の遅れを防ぎます。
冷蔵管理品における“見えない凍結ダメージ”を現場で確実に捉えます。
FreezeSafe
凍結が品質に直結する製品向けに設計され、製品が実際に凍結したかどうかを明確に可視化します。
製品ごとの管理温度に応じた選定が可能で、既存のコールドチェーン運用ルールにも容易に組み込めます。
判定結果は色変化で一目で確認でき、担当者による判断のばらつきを防ぎます。
ColdChain Complete
輸送中の想定外トラブルにも耐える、コールドチェーン管理を実現。
高温・低温の温度逸脱を正確に捉え、シンプルな運用で状況把握が可能です。
時間と温度の管理により、製品品質とコールドチェーンの有効性を確認できます。
Timestrip®社
英国に本社を置き、時間と温度の可視化に特化したインジケータを提供するグローバル企業です。
同社のTTIラベルはシンプルな構造と直感的な表示が特長で、物流現場・食品流通・日常管理用途での使いやすさに優れています。
Timestrip®社商品を見る
Timestrip® PLUS / Timestrip® Food / Timestrip® NEO

Timestrip® PLUS
使用開始からの経過時間を明確に示し、開封後・作業後の温度と経過時間の管理を確実にします。
簡単スタートでコールドチェーンにおける温度異常発生後の品質判断・是正対応を強力にサポートします。
Timestrip® Food
食品の品質変化を温度と時間で可視化する食品向けTTIラベル。
食品流通・物流・販売現場における鮮度管理とロス削減に貢献します。水産物の品質変化に合わせて設計され、低温下での鮮度管理を直感的に支援します。
Timestrip® Neo
小型で軽量の温度変動警告付きLEDラベル。
内蔵センサーとLED表示を用い、温度範囲を逸脱した際に即座に視覚的アラームを発します。
温度精度±0.5℃で輸送・保管中の温度逸脱をリアルタイムで把握でき、商品の品質リスクを素早く察知できます。
Timestrip PLUS® 温度降下検知ラベル FCP



Timestrip® Descending FCP
輸送・保管中に製品が設定温度以下(低温・凍結温度)にさらされたかどうかを不可逆的に可視化する温度下降インジケーターです。
食品・医薬品・コールドチェーンでの低温リスク管理に対応しています。
温度が設定値を下回ると色が緑→赤に変わり、誰でも一目で低温曝露の有無を判定できるシンプルで信頼性の高いラベルです。
TTIラベルの利点
- 温度データロガーでは把握できない累積ダメージの可視化
- クレーム・廃棄リスクの低減
- 品質保証体制の強化
- 顧客・規制当局への説明性向上